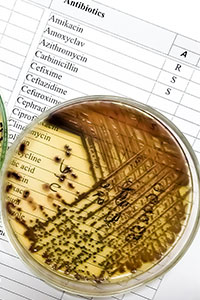
Image

La résistance aux antibiotiques constitue un vrai problème de santé publique. Due à une utilisation mauvaise ou excessive d'un médicament autrefois considéré comme "miracle", elle est la parfaite illustration du concept "One Health".
Sommaire
- Une pandémie silencieuse
- Les antibiotiques : un tournant dans l'histoire de la médecine
- Une voie incontournable
- Élevage et agriculture
- Pollution environnementale
- Attention aux désinfectants !
- Des résistances repérées depuis le début
- Le concept "One Health"
- Un marqueur de l'anthropocène
C'est une réalité du vivant, mise en lumière depuis les découvertes de Darwin. Les bactéries sont capables de s'adapter et de rendre ainsi inefficaces les traitements antibiotiques. Cette résistance est un problème sérieux et représente un risque grave pour la santé publique mondiale : en 2019, l'antibiorésistance était responsable de manière directe de 1,3 millions de décès dans le monde et, de manière associée, de 5 millions.* Un rapport britannique repris par l'OMS (Organisation Mondiale de la Santé) prévoit 10 millions de morts par an dans le monde à l'horizon 2050, liés à cette question.**
Une pandémie silencieuse
L'antibiorésistance "menace de nombreuses avancées médicales qui ont fait reculer les grandes épidémies et ont accompagné le développement de la médecine de pointe"*, s'alarme Claire Harpet, docteure en anthropologie, ingénieure de recherche.
Il s'agirait d'une véritable pandémie silencieuse, selon Jean-Yves Madec, directeur scientifique à l'ANSES (Agence nationale de sécurité sanitaire de l’alimentation, de l’environnement et du travail).**
Les antibiotiques : un tournant dans l'histoire de la médecine
Tout a commencé au début du 20e siècle avec la découverte de la pénicilline par Alexander Fleming, un tournant dans l'histoire de la médecine.
"Après la seconde guerre mondiale les médicaments antibiotiques vont se diversifier, s'industrialiser et révolutionner le monde médical"*, explique Claire Harpet.
Ils sont perçus comme la pilule "miracle" et font partie d'un imaginaire dans lequel l'homme moderne se rêve tout puissant, capable d'échapper à toutes les souffrances.
Une voie incontournable
Voilà qu'il devient possible de combattre et d'éradiquer les infections dues aux bactéries ! On peut donc vaincre la tuberculose, le choléra, la peste, la fièvre typhoïde mais aussi la syphilis, les phlegmons cutanés, les infections urinaires… Et l'on peut aussi éviter les complications post-opératoires dans le domaine de la chirurgie, des greffes.
"La voie antibiotique a très vite été perçue par la communauté biomédicale comme une voie incontournable – voire hégémonique."*
C'est aujourd'hui l'une des plus grandes classes médicamenteuses avec plus de 150 molécules à usage thérapeutique humain.
Élevage et agriculture
Dès le début des années 1950, les antibiotiques sont utilisés également pour les besoins de l'élevage intensif, afin de soigner les animaux d'élevage mais aussi comme promoteurs de croissance (interdits depuis 2006 dans l'Union Européenne).
En agriculture, ils sont également aspergés en grande quantité sur les arbres fruitiers pour combattre des maladies comme le "feu bactérien" des pommiers et des poiriers ou la "maladie du dragon jaune" des agrumes.
Pollution environnementale
Que ce soit dans le domaine médical ou vétérinaire, on assiste ainsi à une sur-utilisation à laquelle s'ajoute un mauvais usage (voir encadré) qui ont, sur la longueur, créé une pollution environnementale notamment dans les milieux aquatiques (voir : Médicaments dans l'eau) et modifié les écosystèmes microbiens. En conséquence, l'antibiorésistance s'est étendue à la faune sauvage.
Attention aux désinfectants !
Les produits ménagers "biocide" participent également à l'émergence de l'antibiorésistance. Ce sont les produits antiseptiques, désinfectants (gel hydroalcoolique, chlore, eau de javel) ou phytosanitaire (pesticides). Ils peuvent créer une résistance chez certaines bactéries qui, par la même occasion, deviennent résistantes à d'autres désinfectants ou à un antibiotique. C'est ce qu'on appelle des phénomènes de résistance croisée.
"Si le nettoyage est indispensable au quotidien, la désinfection, elle, est rarement utile. En effet, la présence de micro-organismes dans notre environnement est normal et même bénéfique pour notre santé : seuls 3 % des bactéries présentes dans notre environnement peuvent causer des maladies"*, affirment Vivien Lecomte et Élodie Brelot, chercheurs au Graie (Groupe de recherche, animation, technique et information sur l'eau).
Des résistances repérées depuis le début
Dans son discours de la cérémonie de remise du prix Nobel en 1945, Alexander Fleming lui-même avait mis en garde contre une utilisation inappropriée de la pénicilline pouvant conduire à la sélection de bactéries résistantes. Depuis, le phénomène a été mis en lumière à de nombreuses reprises : "des résistances sont apparues plus ou moins rapidement après chaque découverte d'un nouvel antibiotique"*, précise Milen Milenkov (Fondation Mérieux à Lyon).
Les effets de résistance microbienne se sont développés jusqu'à l'apparition, dès les années 1960, de bactéries multi-résistantes qui provoquent en milieu hospitalier des infections post-opératoires graves et difficiles à traiter.
Le concept "One Health"
L'antibiorésistance est l'illustration parfaite que la santé des hommes et des animaux ne peut se concevoir indépendamment de celle de l'environnement. Le concept est à la mode et largement médiatisé sous le vocable anglais "One Health".
La question du mésusage serait donc trop limitative. L'antiobiorésistance soulèverait un certain nombre d'écueils propres à notre société : l'uniformisation du soin, la culpabilisation des patients, des éleveurs, des agriculteurs, des médecins et des vétérinaires.
"Derrière ce qui est présenté comme des dérives comportementales individuelles, c'est une profonde crise des institutions de la société de production qui est en jeu"*, conclut Léonie Varobieff, chercheuse à l'IRPhil (Institut de recherches philosophiques de Lyon).
Un marqueur de l'anthropocène
L'antibiorésistance serait même "un marqueur émergent et puissant de l'anthropocène"* (l'ère de l'être humain), selon Antoine Andremont, chercheur à l'Institut national de la santé et de la recherche médicale.
Sources :
*L'antibiorésistance, Un fait social total, Claire Harpet coordinatrice, éditions Quae
**The Conversation : Antibiotiques : "l’antibiorésistance est une pandémie silencieuse"
Santé Magazine : Le bon usage des antibiotiques
En savoir +
"Les antiobiotiques, c'est pas automatique"
La fameuse campagne publicitaire des années 2000 "Les antiobiotiques, c'est pas automatique" montre les efforts de sensibilisation pour aller vers un usage raisonné de ce médicament.
Pour limiter les risques Jean-Yves Madec, directeur scientifique à l'ANSES (Agence nationale de sécurité sanitaire de l’alimentation, de l’environnement et du travail), conseille de jouer sur deux leviers : minimiser la consommation d'antibiotiques et travailler sur des alternatives non médicamenteuses.
"De gros progrès ont été faits sur la zootechnie, la biosécurité : éviter que les microbes n’entrent dans les élevages, construire des circuits isolés, propres, sains…"**
Au niveau des patients, il y a 5 règles d’or à suivre pour une bonne utilisation des antibiotiques…
- Respecter scrupuleusement les doses et la durée du traitement antibiotique qui a été prescrit.
- Prendre le traitement jusqu’au bout, sans écourter la durée même si les symptômes évoluent favorablement.
- Ne pas donner son traitement à quelqu’un d’autre, ou utiliser celui d’une autre personne, même si les symptômes sont similaires.
- Une fois le traitement prescrit terminé, rapporter les comprimés ou le sirop restant à la pharmacie.
- En cas de doute ou d’effets indésirables, demander conseil à son médecin.
Ces dernières années, l'industrie pharmaceutique s'est détournée des recherches sur de nouveaux antibiotiques. D'autres pistes semblent plus prometteuses pour lutter contre l'antibiorésistance.
Découverte en 1917 à l'Institut Pasteur, la phagothérapie, à base de virus bactériophages, est l'une d'entre elles.
D'autres sont à l'étude : l'immunostimulation, de nouveaux vaccins thérapeutiques, l'usage d'anticorps monoclonaux antitoxines, les peptides antimicrobiens…
Sans oublier les simples règles d'hygiène, la prévention, l'alimentation saine, la lutte contre les carences en vitamine D…*
